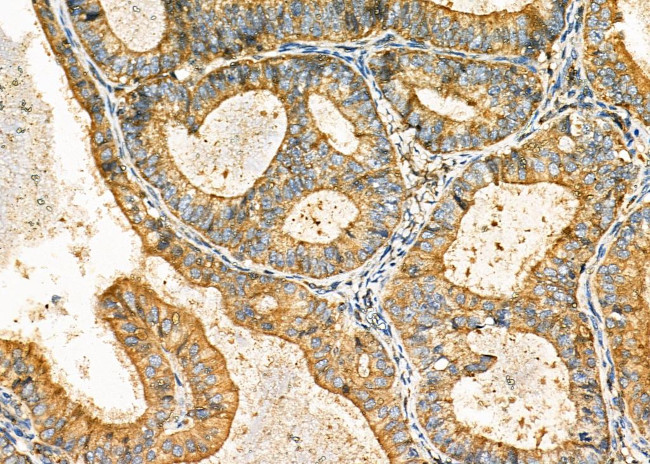
DKK3 Antibody in Immunohistochemistry (Paraffin) (IHC (P))

Search
Invitrogen
DKK3 Polyclonal Antibody
{{$productOrderCtrl.translations['antibody.pdp.commerceCard.promotion.promotions']}}
{{$productOrderCtrl.translations['antibody.pdp.commerceCard.promotion.viewpromo']}}
{{$productOrderCtrl.translations['antibody.pdp.commerceCard.promotion.promocode']}}: {{promo.promoCode}} {{promo.promoTitle}} {{promo.promoDescription}}. {{$productOrderCtrl.translations['antibody.pdp.commerceCard.promotion.learnmore']}}
图: 1 / 8
DKK3 Antibody (PA5-102626) in IHC (P)








Please note: We are reviewing Western blot images included in the antibody testing data in our catalog, including those provided by third parties. Unless expressly labeled or annotated as “raw-unedited”, Western blot images included in the antibody testing data in our catalog may have been edited, optimized or otherwise adjusted for presentation.
产品信息
PA5-102626
种属反应
已发表种属
宿主/亚型
分类
类型
抗原
偶联物
形式
浓度
规格
纯化类型
保存液
内含物
保存条件
运输条件
RRID
产品详细信息
Antibody detects endogenous levels of total DKK3.
靶标信息
DKK3, like DKK1, DKK2, and DKK4, possesses an N-terminal signal peptide and 2 conserved cysteine-rich domains, which are separated by a linker region and contain 10 cysteine residues each. The second cysteine region has a putative lipid-binding function that may facilitate WNT/DKK interactions at the plasma membrane. The linker region contains 50 to 55 amino acids in DKK1, DKK2, and DKK4, whereas in DKK3 it contains only 12 amino acids. All DKKs have several potential sites for cleavage by furin-type proteases. Northern blot analysis revealed wide expression of the DKK3 transcript, with highest expression in heart, brain, and spinal cord. In situ hybridization reveals highest expression in mouse brain, eye, and heart.
仅用于科研。不用于诊断过程。未经明确授权不得转售。
生物信息学
蛋白别名: Dickkopf; dickkopf 3; dickkopf 3 homolog; Dickkopf gene 3; dickkopf homolog 3; Dickkopf-3; Dickkopf-related protein 3; Dickkopf3; DKK 3; dkk-3; hDkk 3; hhDkk3; mDkk-3; Xenopus
基因别名: AW061014; C87148; DKK3; p29; REIC; UNQ258/PRO295
UniProt ID: (Mouse) Q9QUN9
Entrez Gene ID: (Rat) 171548, (Mouse) 50781